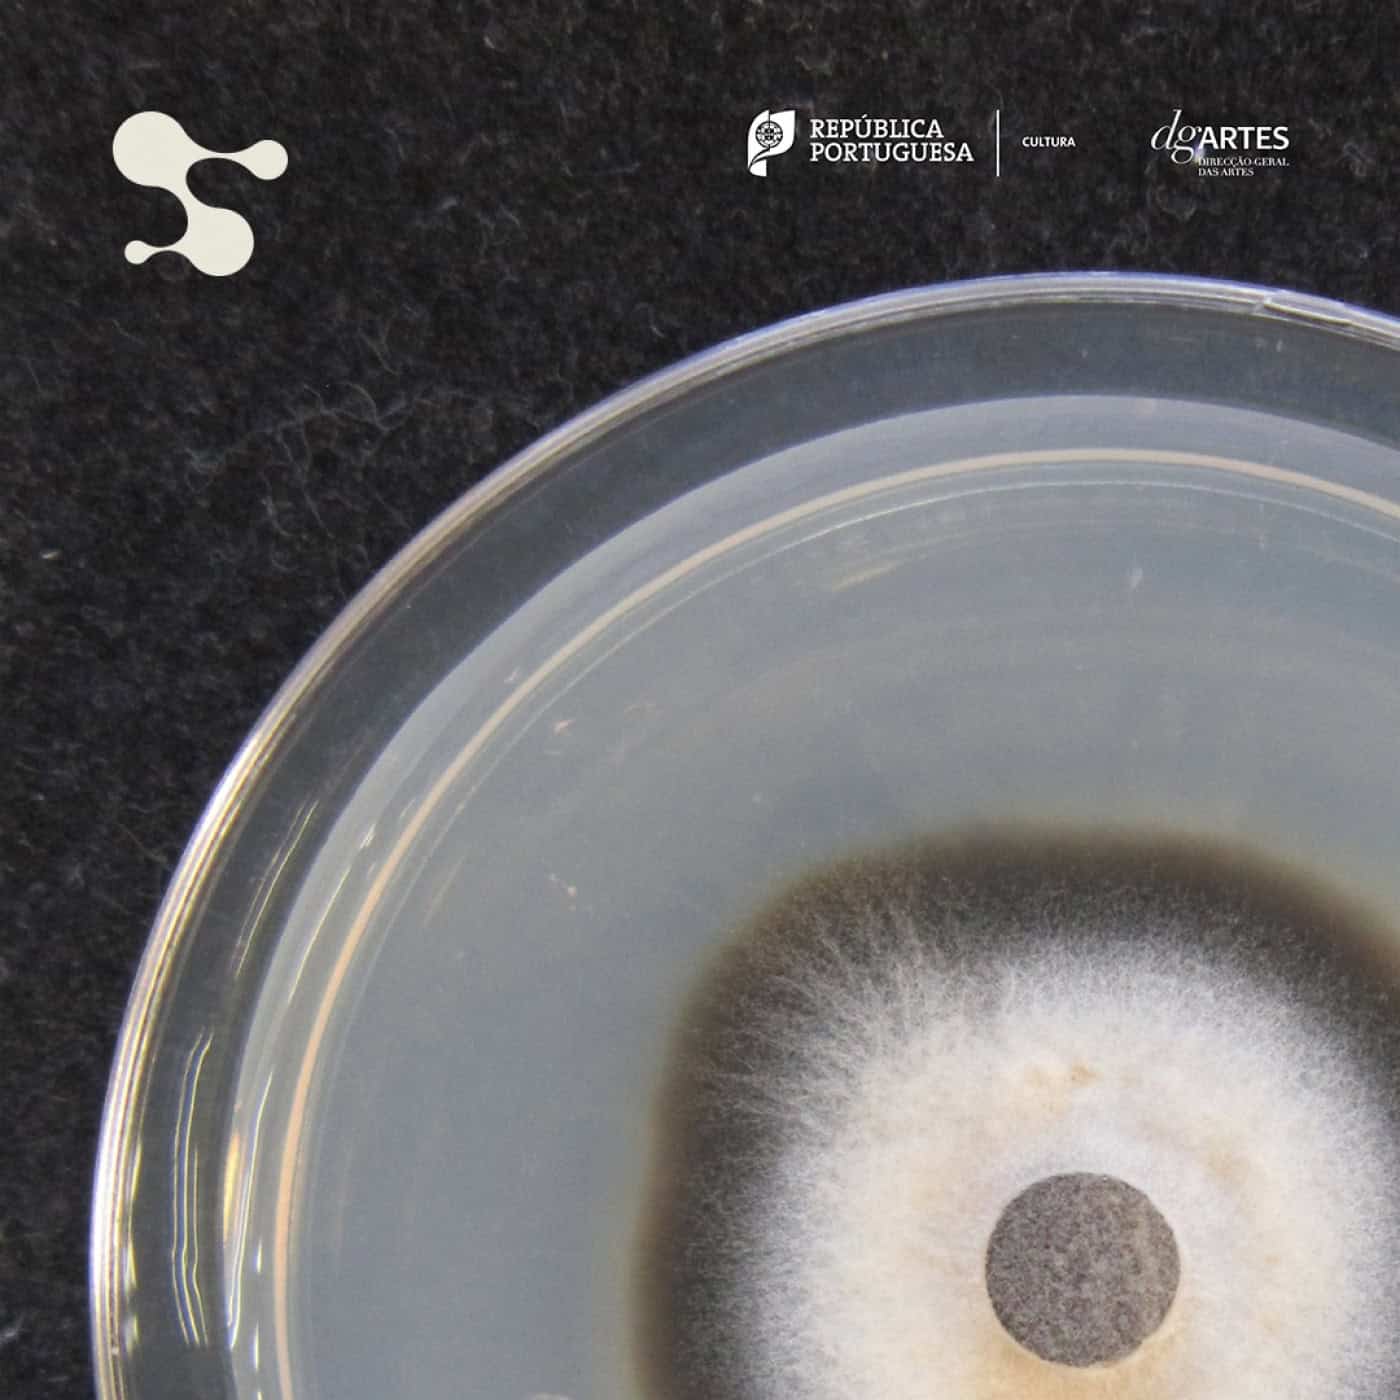
Investigadora da Universidade do Minho inspira performance apresentada em Barcelos

Investigadora da Universidade do Minho inspira performance apresentada em Barcelos
A ciência e a arte juntam-se hoje, sexta-feira, em Barcelos, no Theatro Gil Vicente (21h30), para o espetáculo “Pequeno Mundo”.
A investigadora da Universidade do Minho, Isabel Fernandes, e o coletivo musical Space Ensemble uniram esforços e criaram uma performance que junta a ciência à música, ao vídeo em tempo real, e à dramaturgia.
À RUM, a investigadora do Centro de Biologia Molecular e Ambiental da Escola de Ciências da Universidade do Minho revela que o espetáculo multidisciplinar foi inspirado num “trabalho de campo” no qual os artistas do coletivo conheceram “alguns dos organismos que se podem encontrar nos rios e ribeiros”, objeto de foco da investigação de Isabel Fernandes.
O espetáculo tem direção artística e composição de Samuel Martins Coelho e junta ainda Nuno Preto (ator), António Oliveira e Carina Albuquerque (violoncelos), Daniela Cruz (coreografia), Pedro Teixeira (videógrafo) e Ricardino Lomba (eletrónica).
Sobre a parte sonora, Isabel Fernandes revela que, para as melodias dos violencelos, Samuel Martins Coelho “bebeu não só à investigação mas também ao som da própria água”. A investigadora sublinha que o espetáculo “é aberto a todas as idades”, ainda que a “intepretação dos textos possa ser diferente consoante o olhar de um adulto ou de uma criança”.
Os bilhetes para o espetáculo custam dois euros e podem ser adquiridos na bilheteira do Theatro Gil Vicente.
